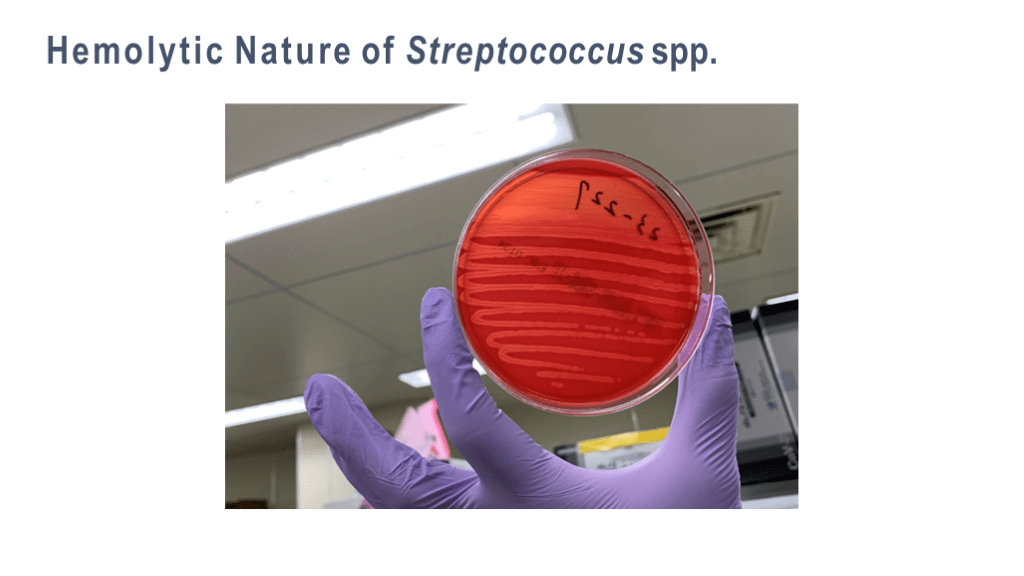

1/38
関連するスライド
「Q&A付き」 " やってみよう!戦略的抗菌薬選択 "
山口裕崇
46166
124
入院患者の発熱の語呂合わせ
関川喜之
19016
145
初期研修医向けグラム陰性桿菌の基本
関川喜之
2916
23
麻疹について最低限・大人のワクチン接種など
nk
17584
68
The first things you learn on the ID rotation
1,958
5
概要
The first things you learn on the ID rotation
本スライドの対象者
専攻医/専門医
投稿された先生へ質問や勉強になったポイントをコメントしてみましょう!
0 件のコメント
横山周平さんの他の投稿スライド
このスライドと同じ診療科のスライド
テキスト全文
IDローテーションの基本と重要性
#1.
Okinawa Chubu Hospital Shuhei Yokoyama, MD The first things you learn on the ID rotation
#2.
Introduction Classically, the field of infectious diseases involves a lot of memorization. Memorizing the spectrum of antibiotic coverage is essential for clinical practice but can be an arduous process. Unlike other medical specialties, the field of infectious diseases is not limited a specific organ. It is our task determine the causative organ that is responsible for infection. At the same time, it is vital to investigate the possible pathogens causing the disease. It is this analytical thought process that is fascinating in this clinical field. The following slides focus on this thought process when facing infectious diseases.
感染性心内膜炎の症例と診断
#3.
A 50yo woman with no significant past medical history (PHx) presented with 2 days of fever and general malaise. On admission, 2 sets of blood cultures (BCx) were taken, revealing gram positive cocci occurring in chains. Further investigation confirmed a diagnosis of infective endocarditis. Physical Exam and Laboratory Results The patient presented with good oral hygiene. There were no apparent oral lesions that could have served as the portal of entry of oral streptococci. However, the GPC was confirmed to be Streptococcus oralis!! During the second interview: The patient mentioned that “she should’ve taken better care of her teeth." She had observed blood from her gums when she brushed her teeth and believed it to be “dirty blood.” It is revealed that she brushed her teeth three times a day, so aggressively that it caused her gums to bleed.
#4.
Approaching Infectious Diseases: Organ Pathogen ABx Patient Hx / PHx, should be taken. Laboratory tests should be performed with the following in mind: ①Organ involvement ②Causative organism ③Likely diagnosis If an infection is suspected: 2 sets of blood cultures (BCx) must be taken and the gram stain must be performed. Taking Patient Hx + Physical Examination + Lab(L/D, Imaging etc.) ※Relevant positive/negative findings Principles of Selection: Efficacy Narrow spectrum Organ distribution Adverse effect Affordability (low price) Taking Patient Hx + Gram stain/Culture + Lab(Culture, Ag/Ab, PCR)
肺炎の原因菌とその特徴
#5.
Key Elements ofPneumonia Follow-up Organ Pathogen ABx Lung Chest ex) imaging, lab findings →TB, HIV S. aureus→Infective endocarditis ① RR ② Volume of sputum ③ Gram stain Patient Hx
#6.
Common organisms that cause pneumonia Streptococcus pneumoniae Haemophilus influenzae Moraxella catarrhalis Klebsiella pneumoniae Pseudomonas aeruginosa Staphylococcus aureus
#7.
Streptococcus pneumoniae 23.2% of community-acquired pneumonia. GPDC; gram-positive lancet-shaped diplococci. Lancet form Halos are capsular membranes that may be present around the bacillus. The gram stain reveals a transparent zone surrounding the organism.
#8.
Haemophilus influenzae 18.6% of community-acquired pneumonia. GNCB; gram-negative coccobacilli. Small size It is difficult to distinguish whether they are a coccus or bacillus due to their small size.
#9.
Moraxella catarrhalis 6.1% of community-acquired pneumonia. GNDC; gram-negative coccobacilli. Kidney-shaped Phagocytic image is remarkable. It is impossible to distinguish it from other species such as Neisseria meningitidis or Acinetobacter spp. by its shape alone.
#10.
Klebsiella pneumoniae 3.4% of community-acquired pneumonia. GNR-large(GNlR); gram negative large rod. Box-shaped, stubby, blunted circle. Pink mucoids may be observed around the bacillus. Mucoid can also be seen in P.aeruginosa.
#11.
Pseudomonas aeruginosa 3.7% of community-acquired pneumonia. GNR-small(GNsR); gram-negative small rod. It is thinner than E.coli. It is can be confused with other gram-negative rods due to the presence of pink mucoids that masks its “thin body” characteristic.
#12.
Staphylococcus aureus 0.6% of community-acquired pneumonia. GPC-cluster; gram-positive cocci occurring in clusters. No morphological distinction can be made between MSSA and MRSA.
多因子感染とグラム染色の重要性
#13.
Polymicrobial Infections When both gram positive and gram negative bacteria are found in large numbers, it is difficult to determine the dominant causative organism. Aspiration pneumonia is suspected when both polymorphonuclear leucocytes (PMN) and numerous squamous epithelial (Epi) are seen.
#14.
Mycobacterium tuberculosis Acid fast bacilli (AFB)
#15.
Gram stain The causative pathogen can be predicted by organ involvement and patient history. The true Identity of the organism can only be determined by the results of the culture, which can take several days to complete. Gram staining is a quick and cheap method to narrow down the likely causative organisms. To become proficient at gram staining, it is vital to have viable specimens, a place to perform the stain, an instructor, and most importantly, ample practice.
尿路感染症の重要な要素とリスク評価
#16.
Key Elements of Urinary Tract Infections Patient Hx Follow-up Organ Cystitis Pyelonephritis(+ureteral stones) Prostatitis Epididymitis Catheter-related UTIs Abx ① Costovertebral angle tenderness ② Gram stain ③ Look for signs of abscess or obstruction (if treatment course remains unsatisfactory) Pathogen
#17.
Microscopic Images of GNR (The Limitations of Gram Staining) Enterobacter cloacae Pseudomonas aeruginosa Serratia marcescens Klebsiella pneumoniae Serratia marcescens Klebsiella pneumoniae Escherichia coli Pseudomonas aeruginosa
#18.
Common in the community: PEK; Proteus, E.coli, Klebsiella Non-fermenting bacteria (=commonly seen in device-related infection) Pseudomonas, Acinetobacter Wet Environments (commonly seen in hospitals and nursing care institutes) PM-SEC; Providencia, Morganella, Serratia, Enterobacter, Citrobacter This group has autosomal β-lactamase (AmpC) that hydrolyzed cephalosporins ESBL This β-lactamase is present in the plasmid and degrades penicillin and cephalosporin AmpC AmpC is induced by abx exposure and is produced in excess in these organisms. It confers a wide spectrum of resistance against penicillin and cephalosporin MDRP P. aeruginosa that is resistant to all types of carbapenems, quinolones, and aminoglycosides Carbapenem-resistant Enterobacteriaceae These strains produce carbapenemase known as CPE. Enterobacteriaceae AMR (Antimicrobial resistance)
#19.
Water supply and drainage systems The gram stain of pus from near tracheal foramen Catheter-related bloodstream infection Cutaneous fistula, infection near the tracheal foramen Catheter-related UTI P. aeruginosa on the water faucet
#20.
Assessing the Risk of AMR Recent history of antimicrobial treatment (including outpatient oral antimicrobials) Recent hospitalization Patients that are referred from other medical facilities or residential care facilities (nursing homes, etc.) Medical devices: urinary catheters, indwelling intravascular catheters, intubation, cardiovascular implantable devices (pacemakers, etc.) Nosocomial infection Steroids, immunosuppressive therapy History is significant for drug-resistant bacteria
患者歴の取り方と社会的背景
#21.
Key Elements of Patient History Taking: Listen to the patient while taking into consideration the differential diagnoses (organ, organism). Gather relevant information (relevant positive/negative findings) Predict the results before they become available Routine tests may mask relevant clues → is it necessary? Epidemiologic information (endemic infections, sick contacts, overseas travel), Lifestyle, activity, exposure (food, animal, insect, water contact/exposure)
#22.
Social History Place of birth Education Occupation Alcohol, tobacco, illicit drug use Patient’s daily activities Socioeconomic status Support from others (from whom and what) Eating habits, hygiene, toileting Social welfare facilities (ex. nursing home) Sick contact Dental care Health maintenance visits Food (raw food, seafood, meat, dairy products) Animal exposure Previously treated for tuberculosis
旅行歴と感染症の関連性
#23.
Social History
#24.
A 21yo man with no significant past medical history complained of fever with chills that began 2 days ago. He returned from India 3 days ago where he spent 2 weeks there. He claimed to have swum in the Ganges River. He was not vaccinated prior to travel. Travel history to India Exposure to the Ganges River Unvaccinated Diagnosis: Typhoid fever
皮膚・軟部組織感染の要素と細菌の特性
#25.
Refine the Symptom List, Develop the Assessment Fever for 2 days travel history to India exposure to the Ganges unvaccinated Sherlock Homes lay down and studied the ground with his magnifying glass. Just as the clues lead to solving the crime, the chief complaints lead to the diagnosis.
#26.
History of Overseas Travel Locations visited (including stopovers) The condition of the lodging (urban or rural) Climate, season Exposure to insects, spiders, ticks, reptiles, and mammals (bite, sting) Exposure to animals (bite, lick) Contact with people who are unwell Travel itinerary(departure and return dates) • Sexual activity without barrier protection Food and drink (location, preparation, etc.) Vaccination prior to travel Forms of travel (cruise ship, package tour, backpacking) Injury, illness, treatment (referral letter?) https://www.fitfortravel.nhs.uk/home
#27.
Key Elements of Skin / Soft Tissue Infection Patient Hx Follow-up Organ Pathogen Epidermis Dermis Subcutaneous fat Fascia Others (hair follicle, follicular) ABx ① Local pain, heat, swelling, redness ② Wrinkling ③ Itching
#28.
Streptococcus spp. α hemolytic (incomplete hemolysis) β hemolytic (complete hemolysis) high virulence γ hemolytic(non- hemolysis) (currently classified separately) low virulence α-Streptococcus S.pneumoniae α hemolytic, but exceptionally virulent pneumonia, sinusitis, otitis media, meningitis etc. Viridans streptococci ; S.anginosus group,S.mutans, S.gallolyticus, S. sanguis, S. mitis etc. Infective endocarditis, dental infections, brain abscess, β-Streptococcus (Lancefield) A (GAS) C (GCS) G (GGS) S.pyogenes pharynx B (GBS) S.agalactiae vagina S.dysgalactiae subsp. equisimilis Enterococcus spp. Enterococcus faecalis Enterococcus faecium ・Infective endocarditis Enterococcus IE is treated wth 2 Abx over a longer period of time as it has a tendency to recur. ・Cholecystitis, cholangitis, peritonitis etc. →Even if it detected, it may not be a target for treatment pharingitis, tonsilitis, necrotizing fasciitis meningitis in newborns Cellulitis
感染症の診断における重要な要素
#29.
Hemolytic Nature of Streptococcus spp.
#30.
Staphylococcus spp. Coagulase Staphylococcus aureus positive Coagulase negative Staphylococcus lugdunensis Staphylococcus saprophyticus Others MSSA MRSA Part of the human skin flora Cellulitis, IE, osteomyelitis, discitis, arthritis, device infection etc. CNS, highly pathogenic (treat as S. aureus) cause of pyelonephritis in young women CA-MRSA is increasingly common highly pathogenic Susceptible for ST, CLDM Anti-MRSA ABx
#31.
Key-Elements of Infectious Diseases Patient Hx Follow-up Organ Pathogen ABx Search for fever + “key” information: ① History taking ② Physical examination ③ Typical clinical course ① Gram stain ② Culture age, standard of living, lifestyle, underlying medical conditions, immunodeficiency, behavioral patterns, travel history, surgical history, medical devices, animal contact etc. ① Clinical course ② Focus on organ-specific symptoms Caution!! body temperature , WBC count, and CRP can be misleading. From the patient hx: Predict organ involvement and the possible causative organisms From the organism: Predict the likely underlying disease / condition and organ involvement Abx Selection Principles Efficacy Narrow spectrum Organ distribution Adverse effect Affordability (low price)
臨床的考察と患者へのアプローチ
#32.
”The fever was not caused by an infection!!"Words of caution regarding fever: General characteristics of bacterial infections: Acute febrile disease Most patients present within 1-2 days of fever With shaking chills (shivering) Worsening condition The course of infection is either Crescendo or Decrescendo “Neither better nor worse” is not characteristic of a bacterial infection Difference between the left and right sides: ex) Right CVA tenderness → Right pyelonephritis Do not overly rely on body temperature, WBC count, or CRP Point ① Do not overly rely on appearances Point ② Do not carelessly prescribe Abx Point ③ The case will become much more difficult to handle if there is a background of inappropriate Abx exposure.
#33.
Useful Tip: areas to reexamine after initial investigation The patient may not have been previously examined in these areas: Head Sinus Oral mucosa Gum Ear Thorax - Auscultation from the back Genital area - epididymis scrotum perianal region Skin - Observe every part of the skin (Did you see the buttocks too?)
#34.
Ecthyma gangrenosum Skin lesions on the buttocks. The patient presented to the hospital with a chief complaint of fever. As he was embarrassed about his illness, he did not show the painful lesion on his buttocks during his initial visit. Later, it was found to be acute leukemia. Ecthyma gangrenosum on the buttocks
#35.
Clinical cases in which signs may not be readily found:
#36.
Summary Always keep the differentials in mind when taking the patient history and performing the physical examination. It is crucial to anticipate the organs and pathogens that may be involved. Refine the list of chief complaints and develop the initial assessment. Further investigate the patient’s background (activity, occupation, contact & exposure) to determine the reason why the pathogen caused the infection. Once the diagnosis is made, advise the patient on how to prevent reinfection. Always consider the patient’s point of view. It is vital to determine what the patient’s goals are for treatment and recovery. It is of utmost importance to provide quality medical care to patients, their families, and society. We hope you have a rewarding clinical experience, and don’t forget to have fun!
#37.